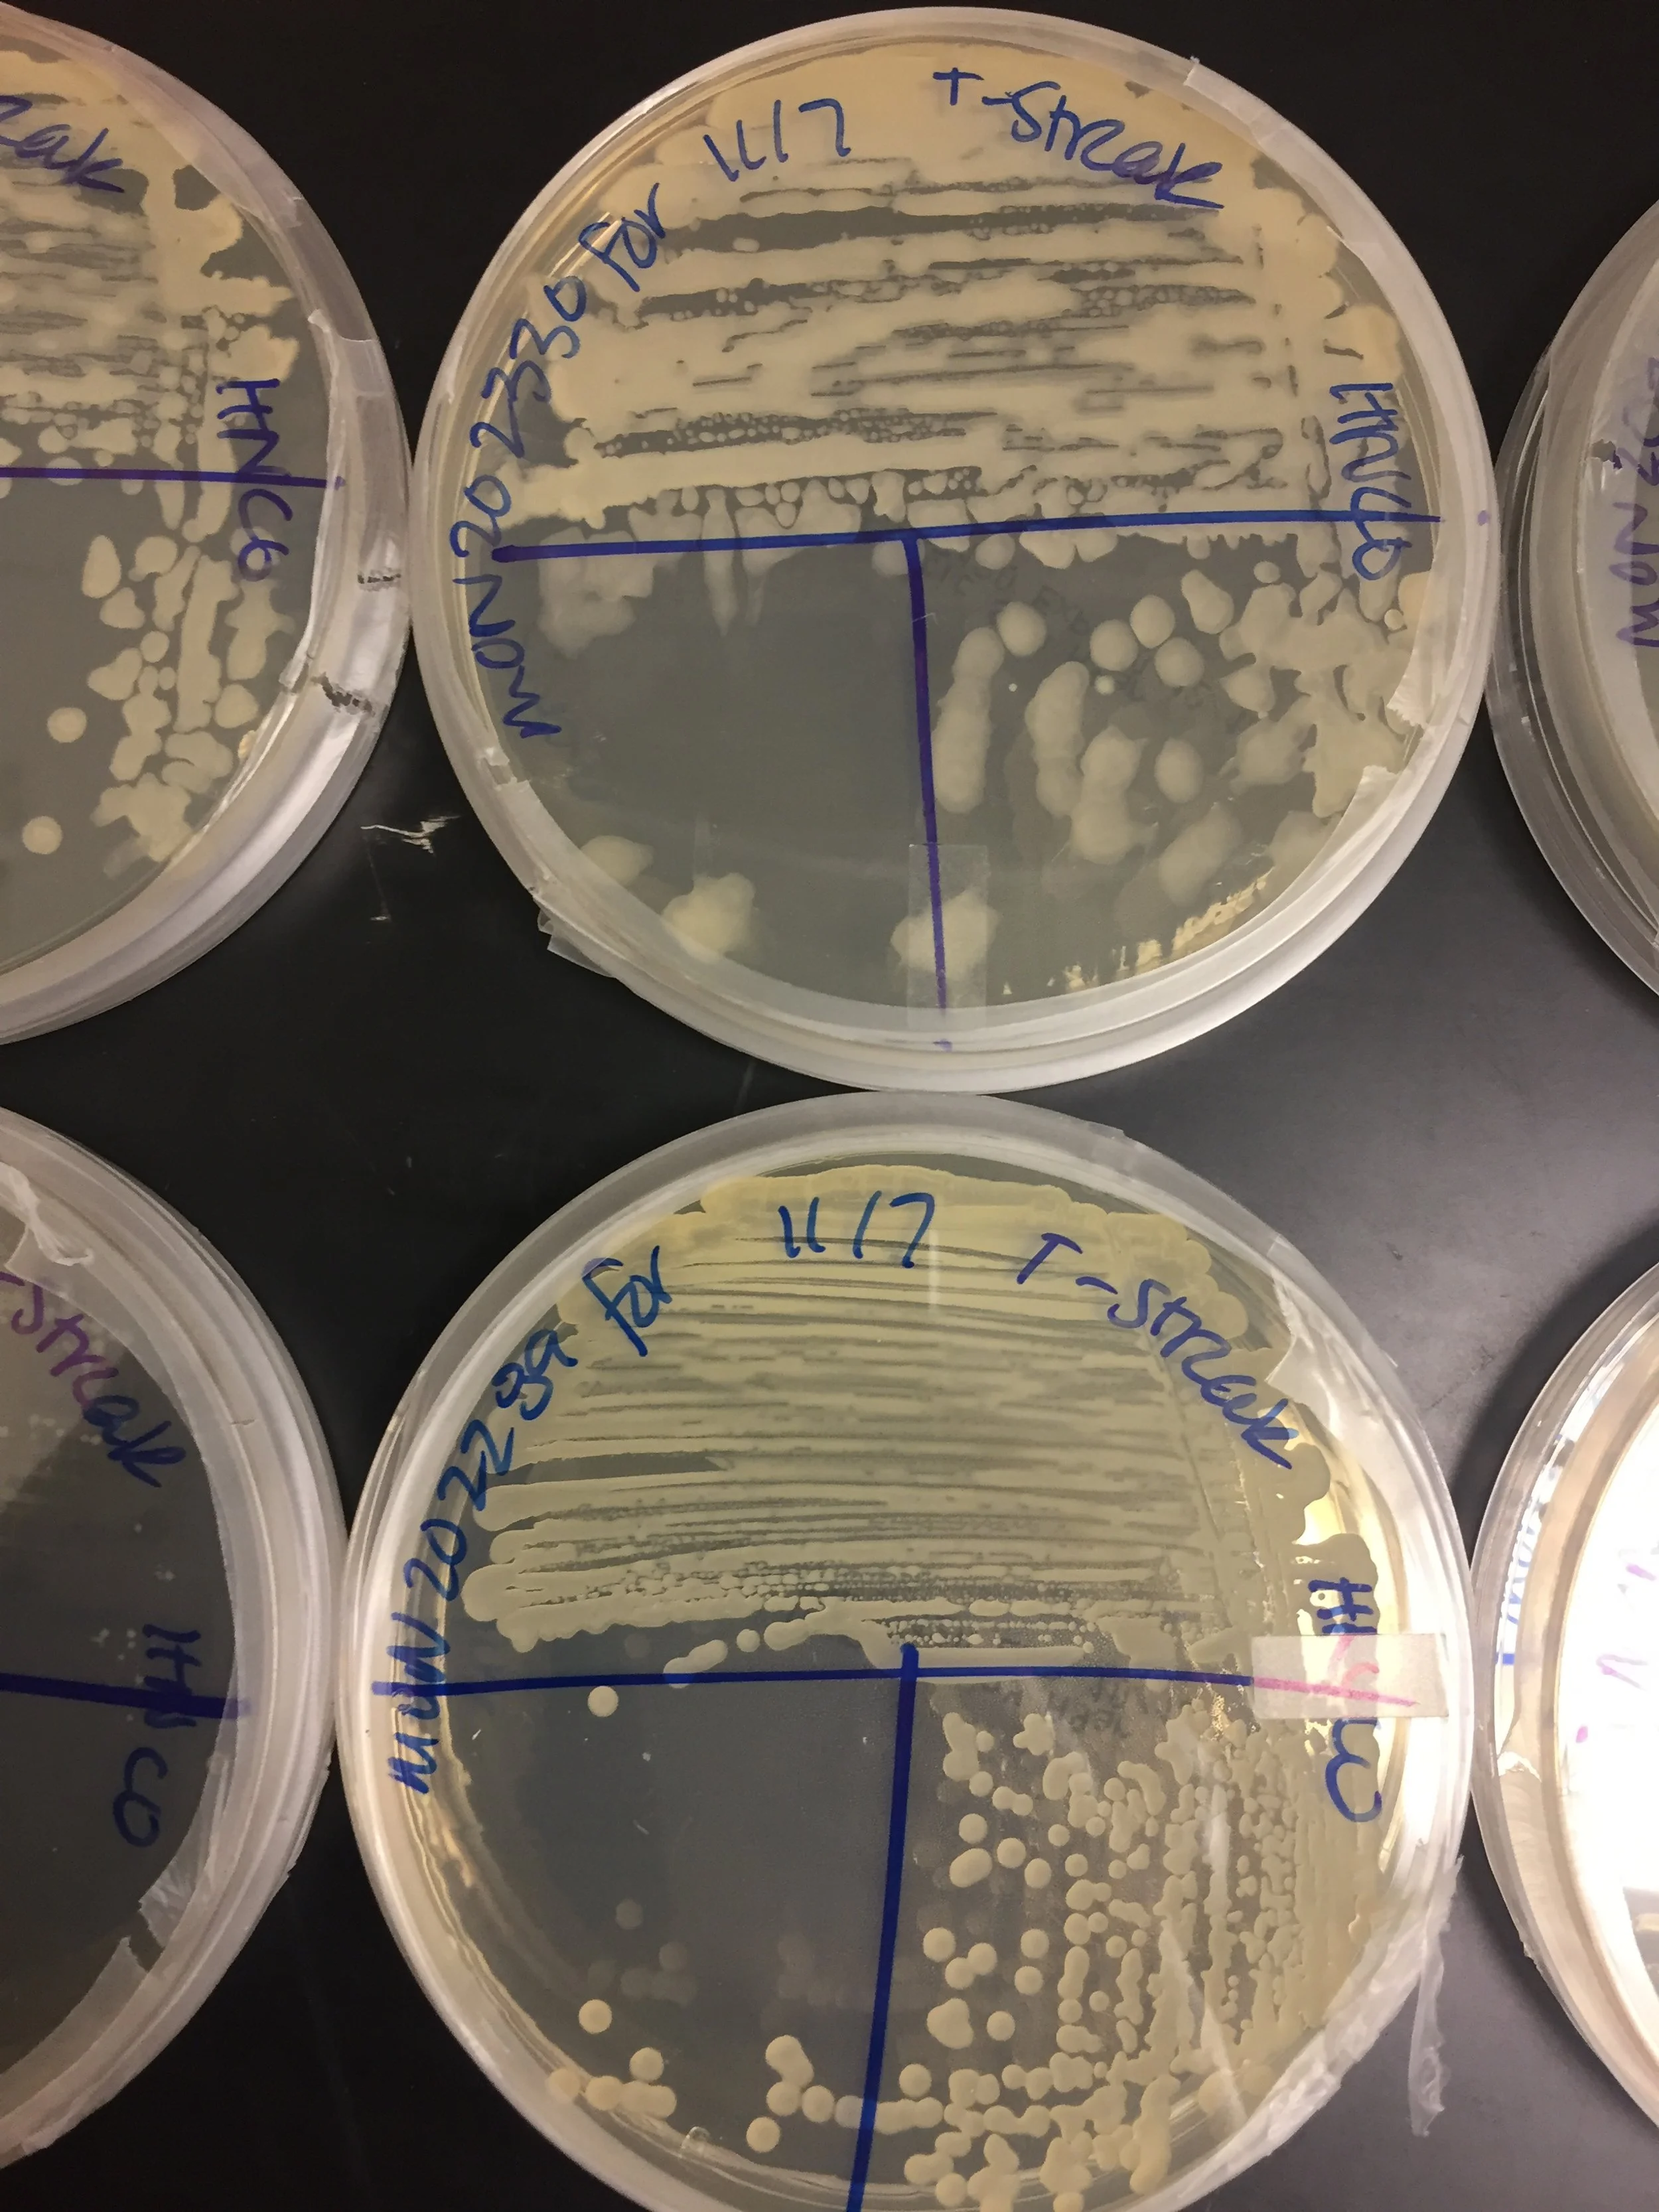
20181108_163342914_iOS.jpg
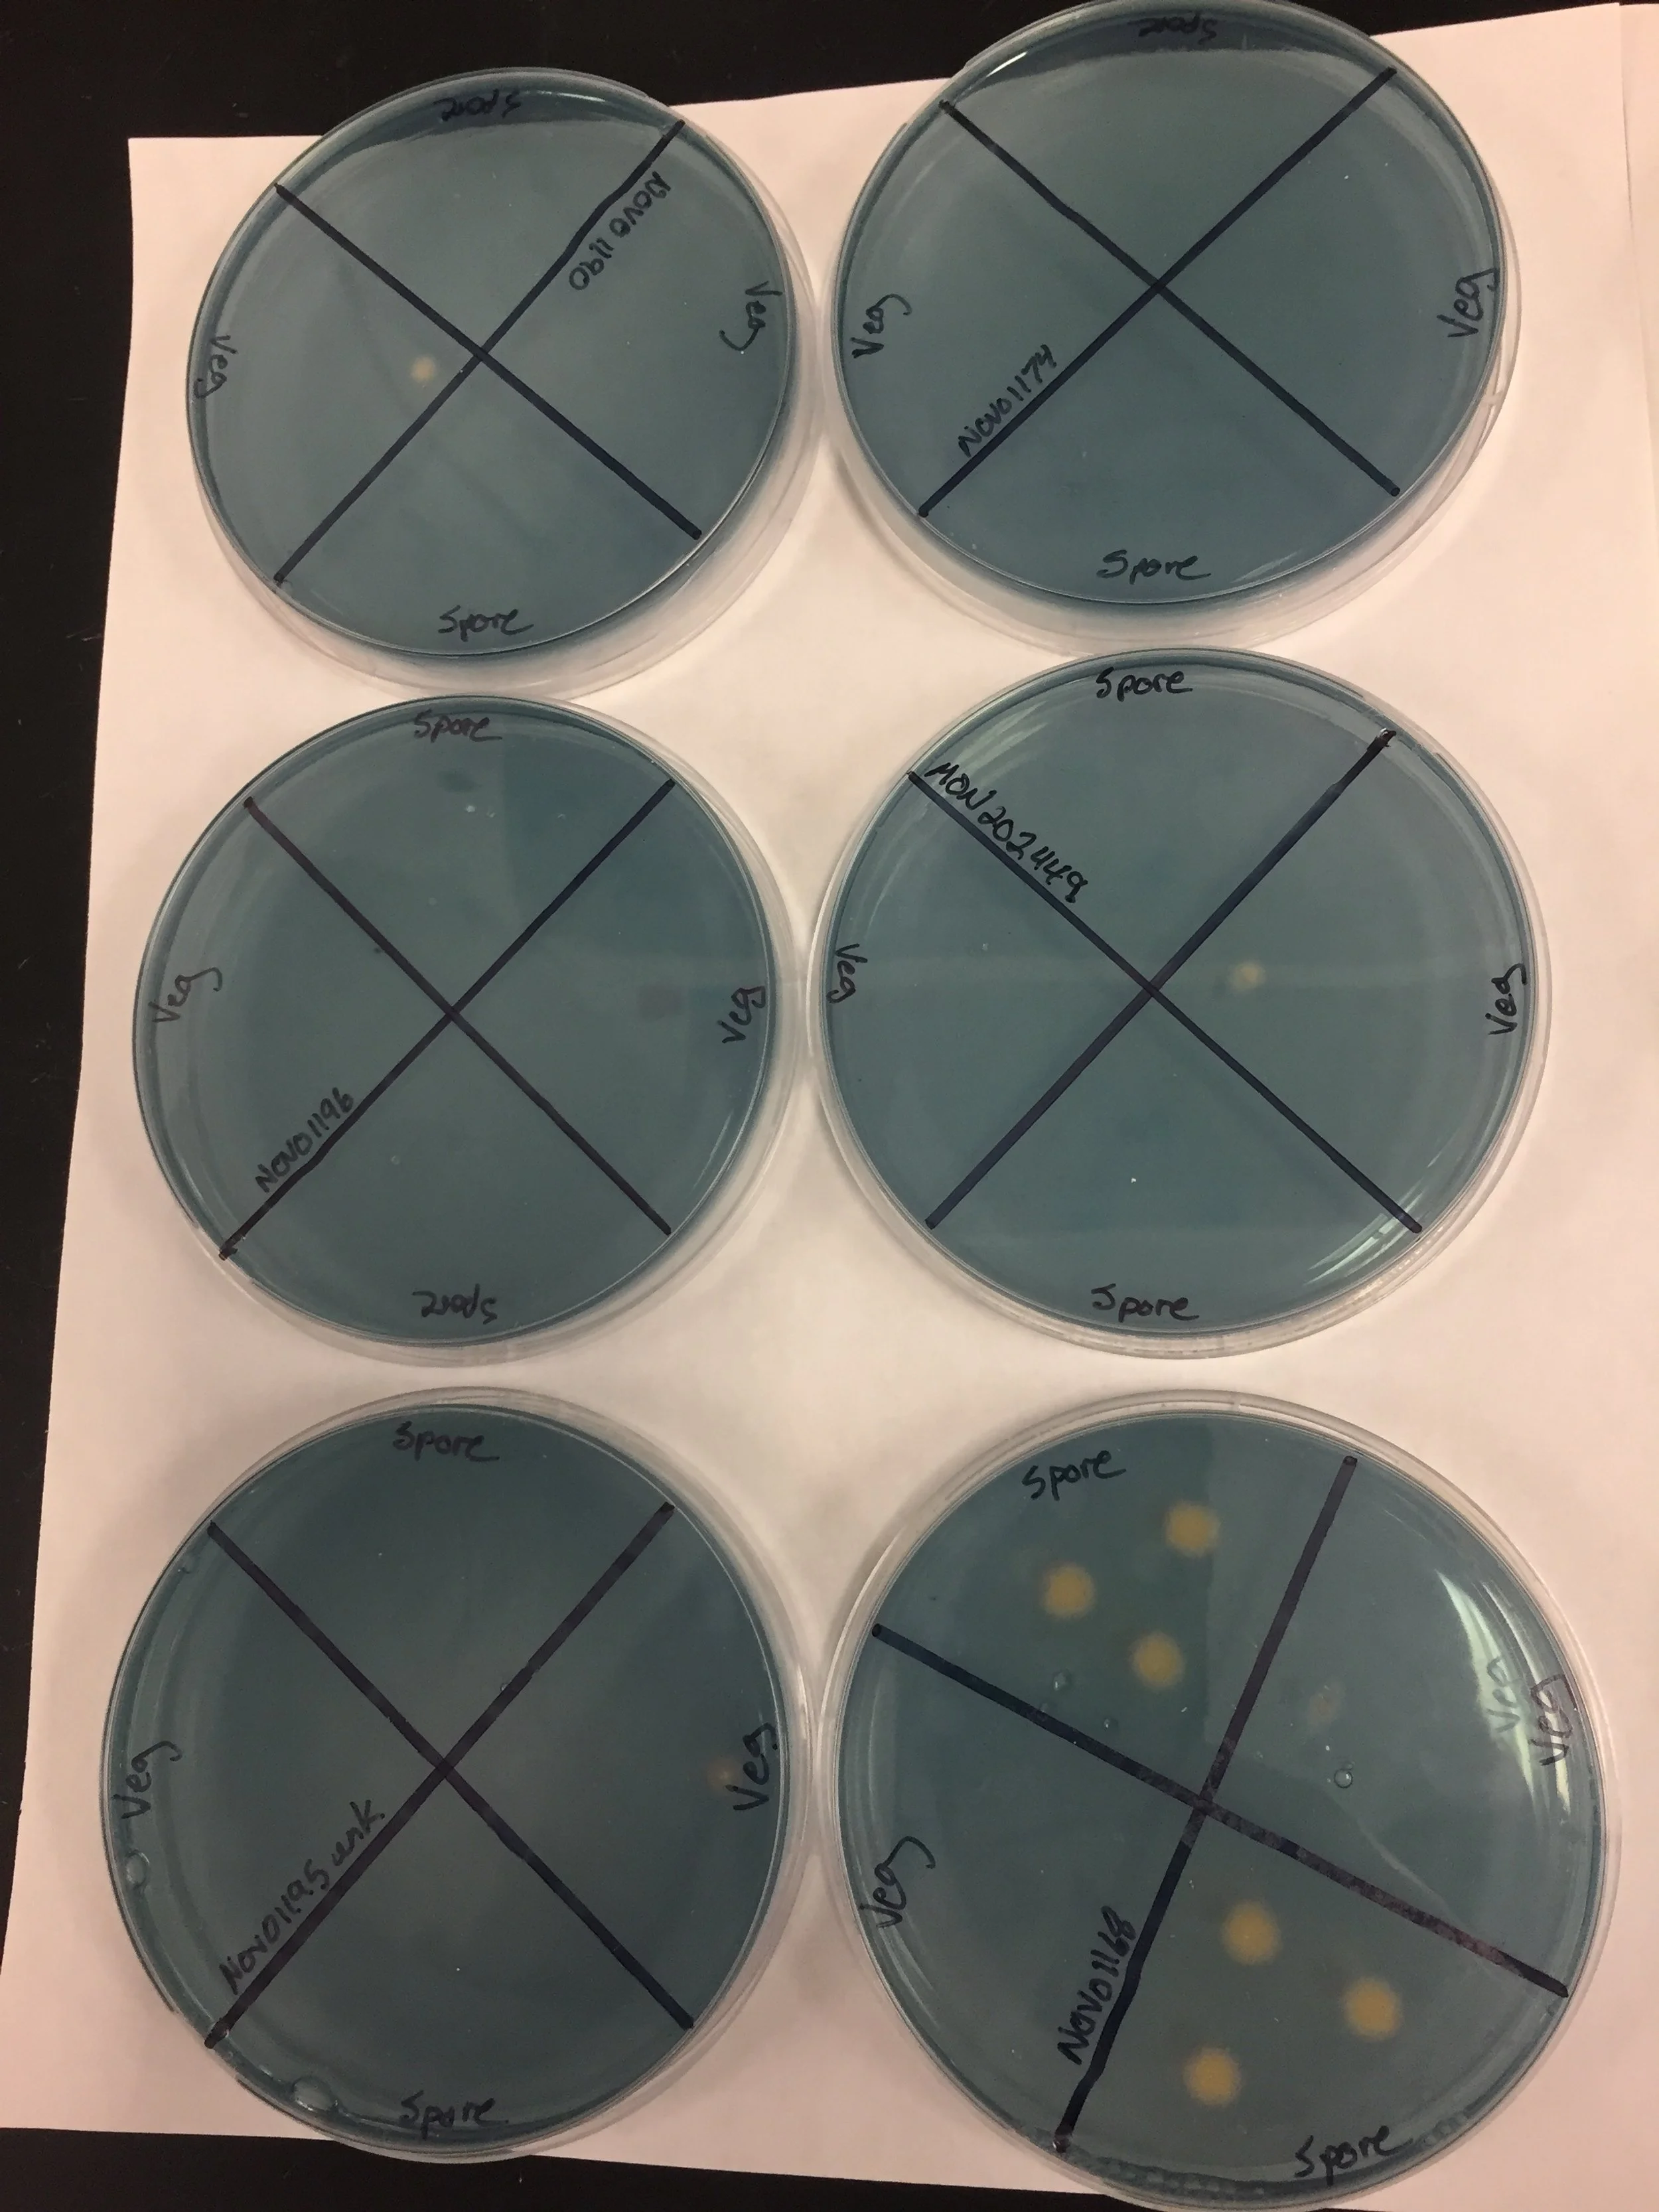
20190201_152059528_iOS.jpg
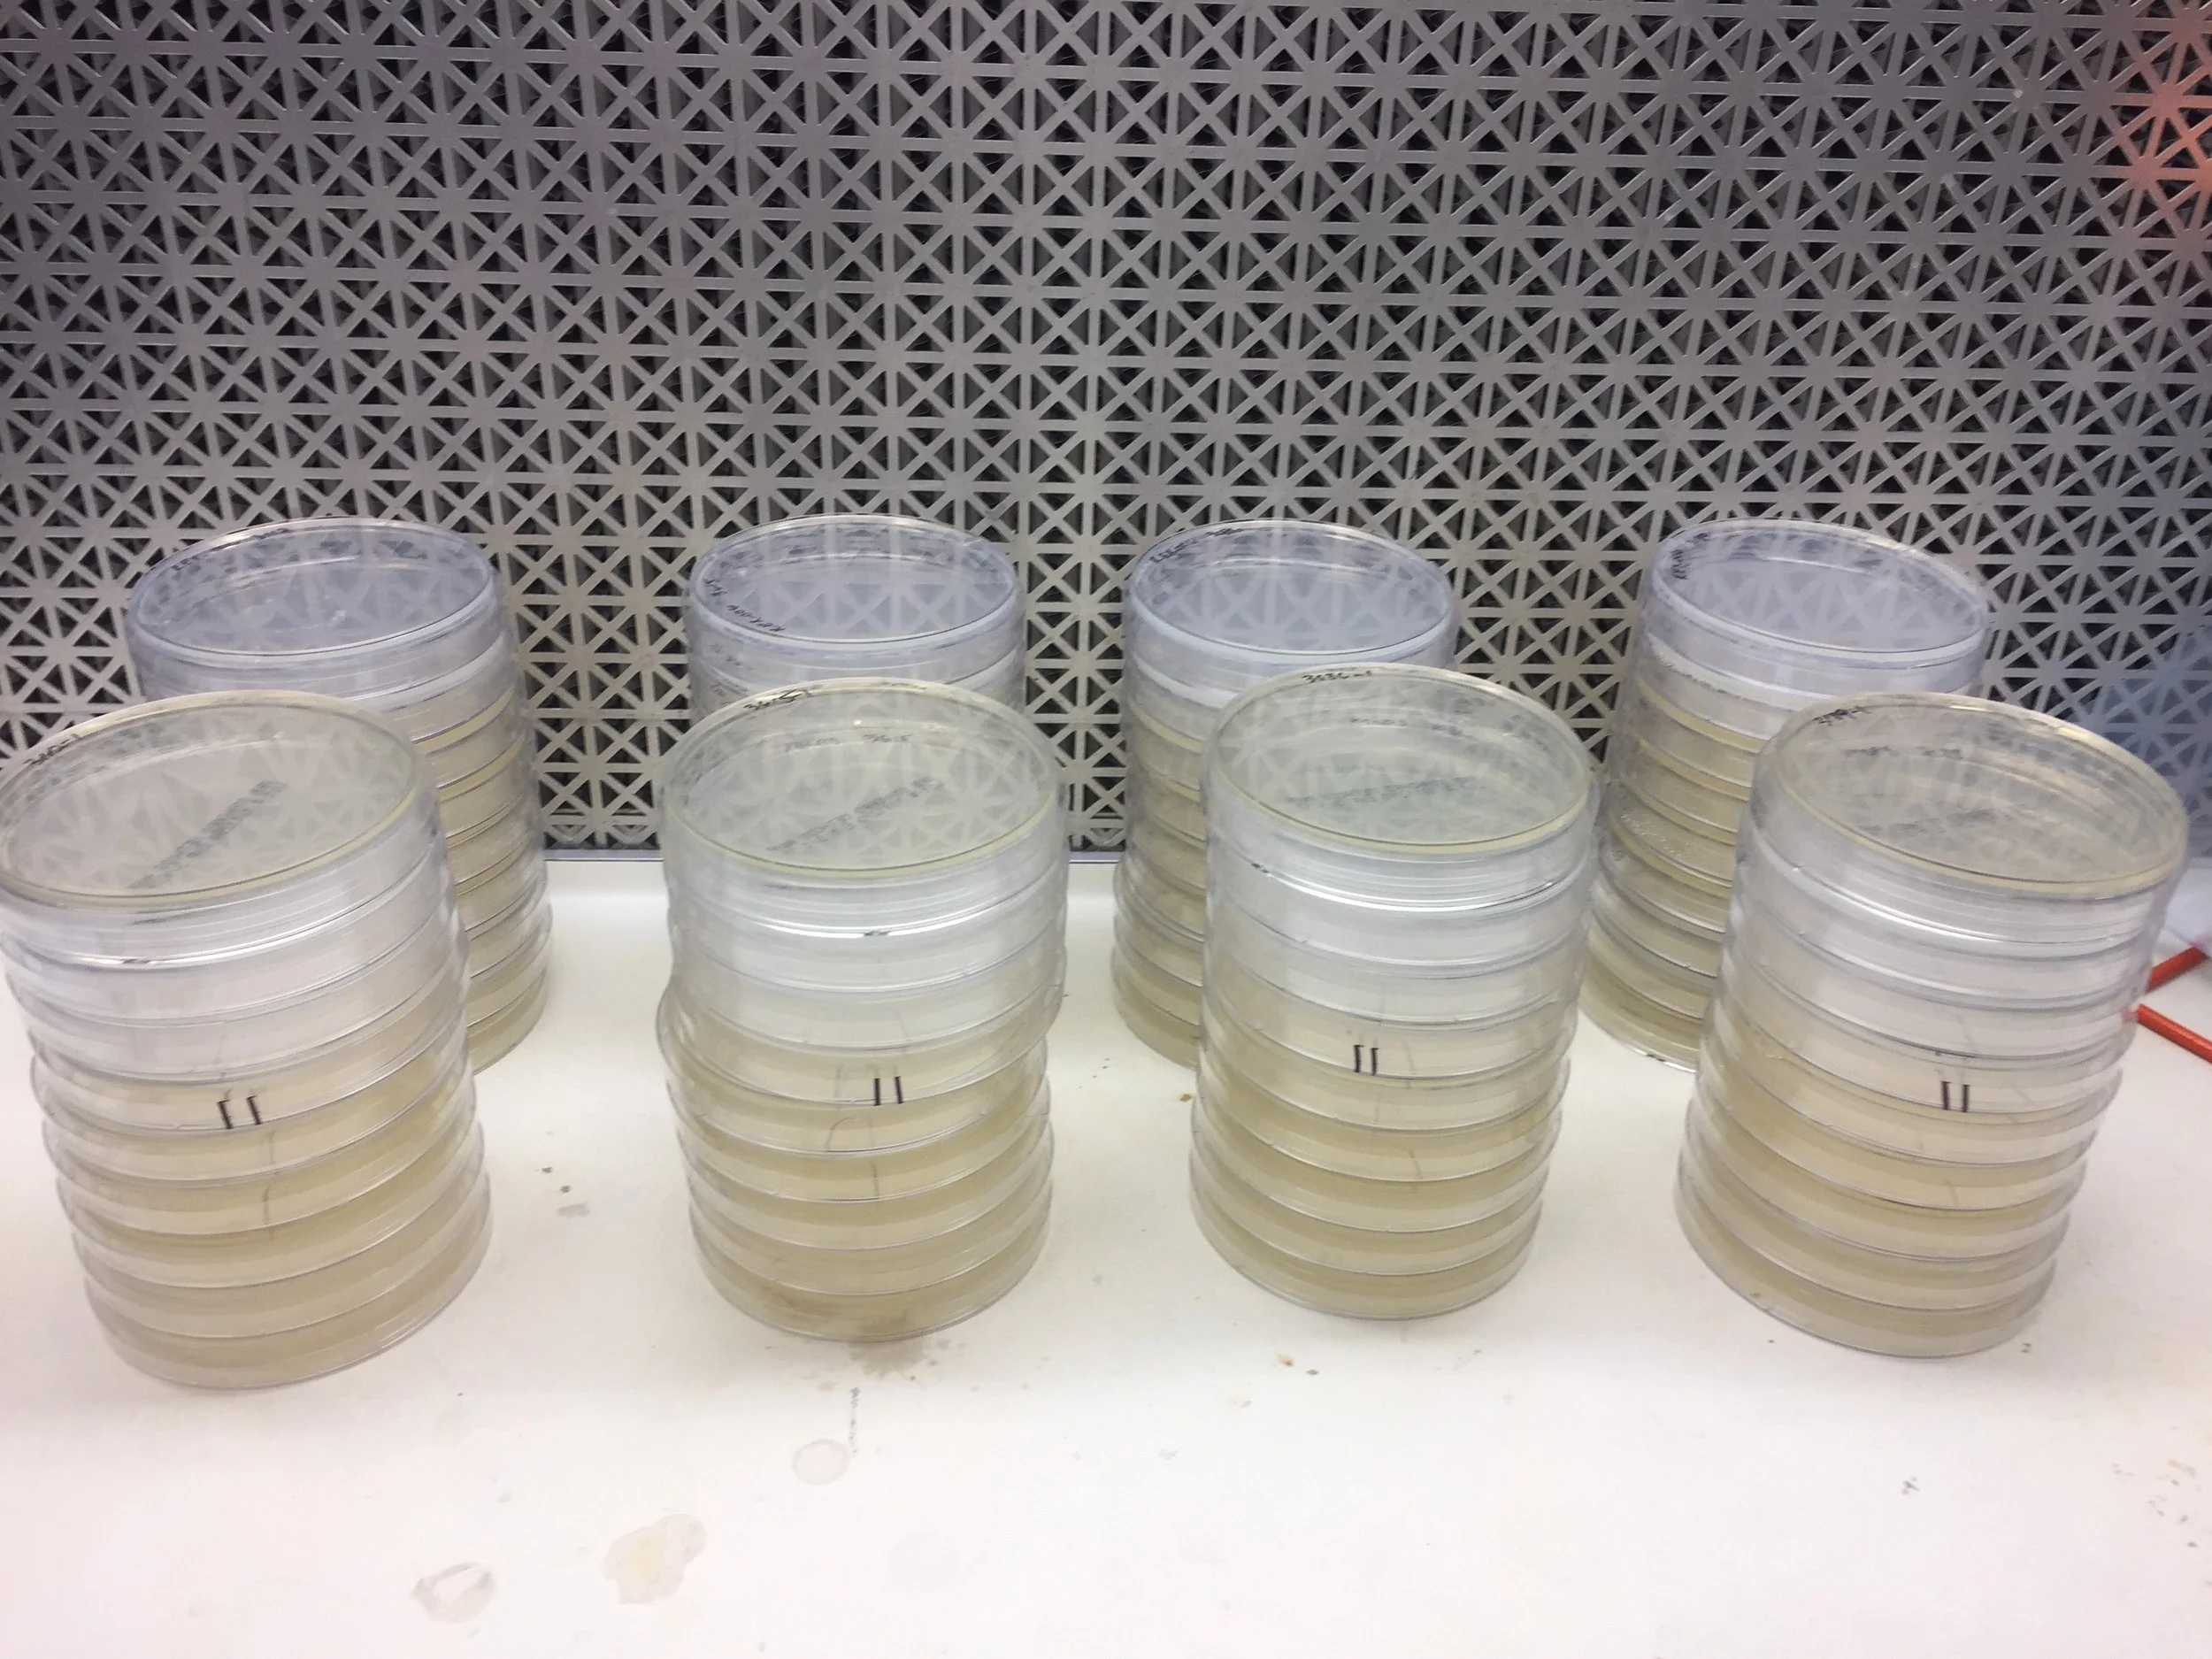
20190225_191112785_iOS.jpg
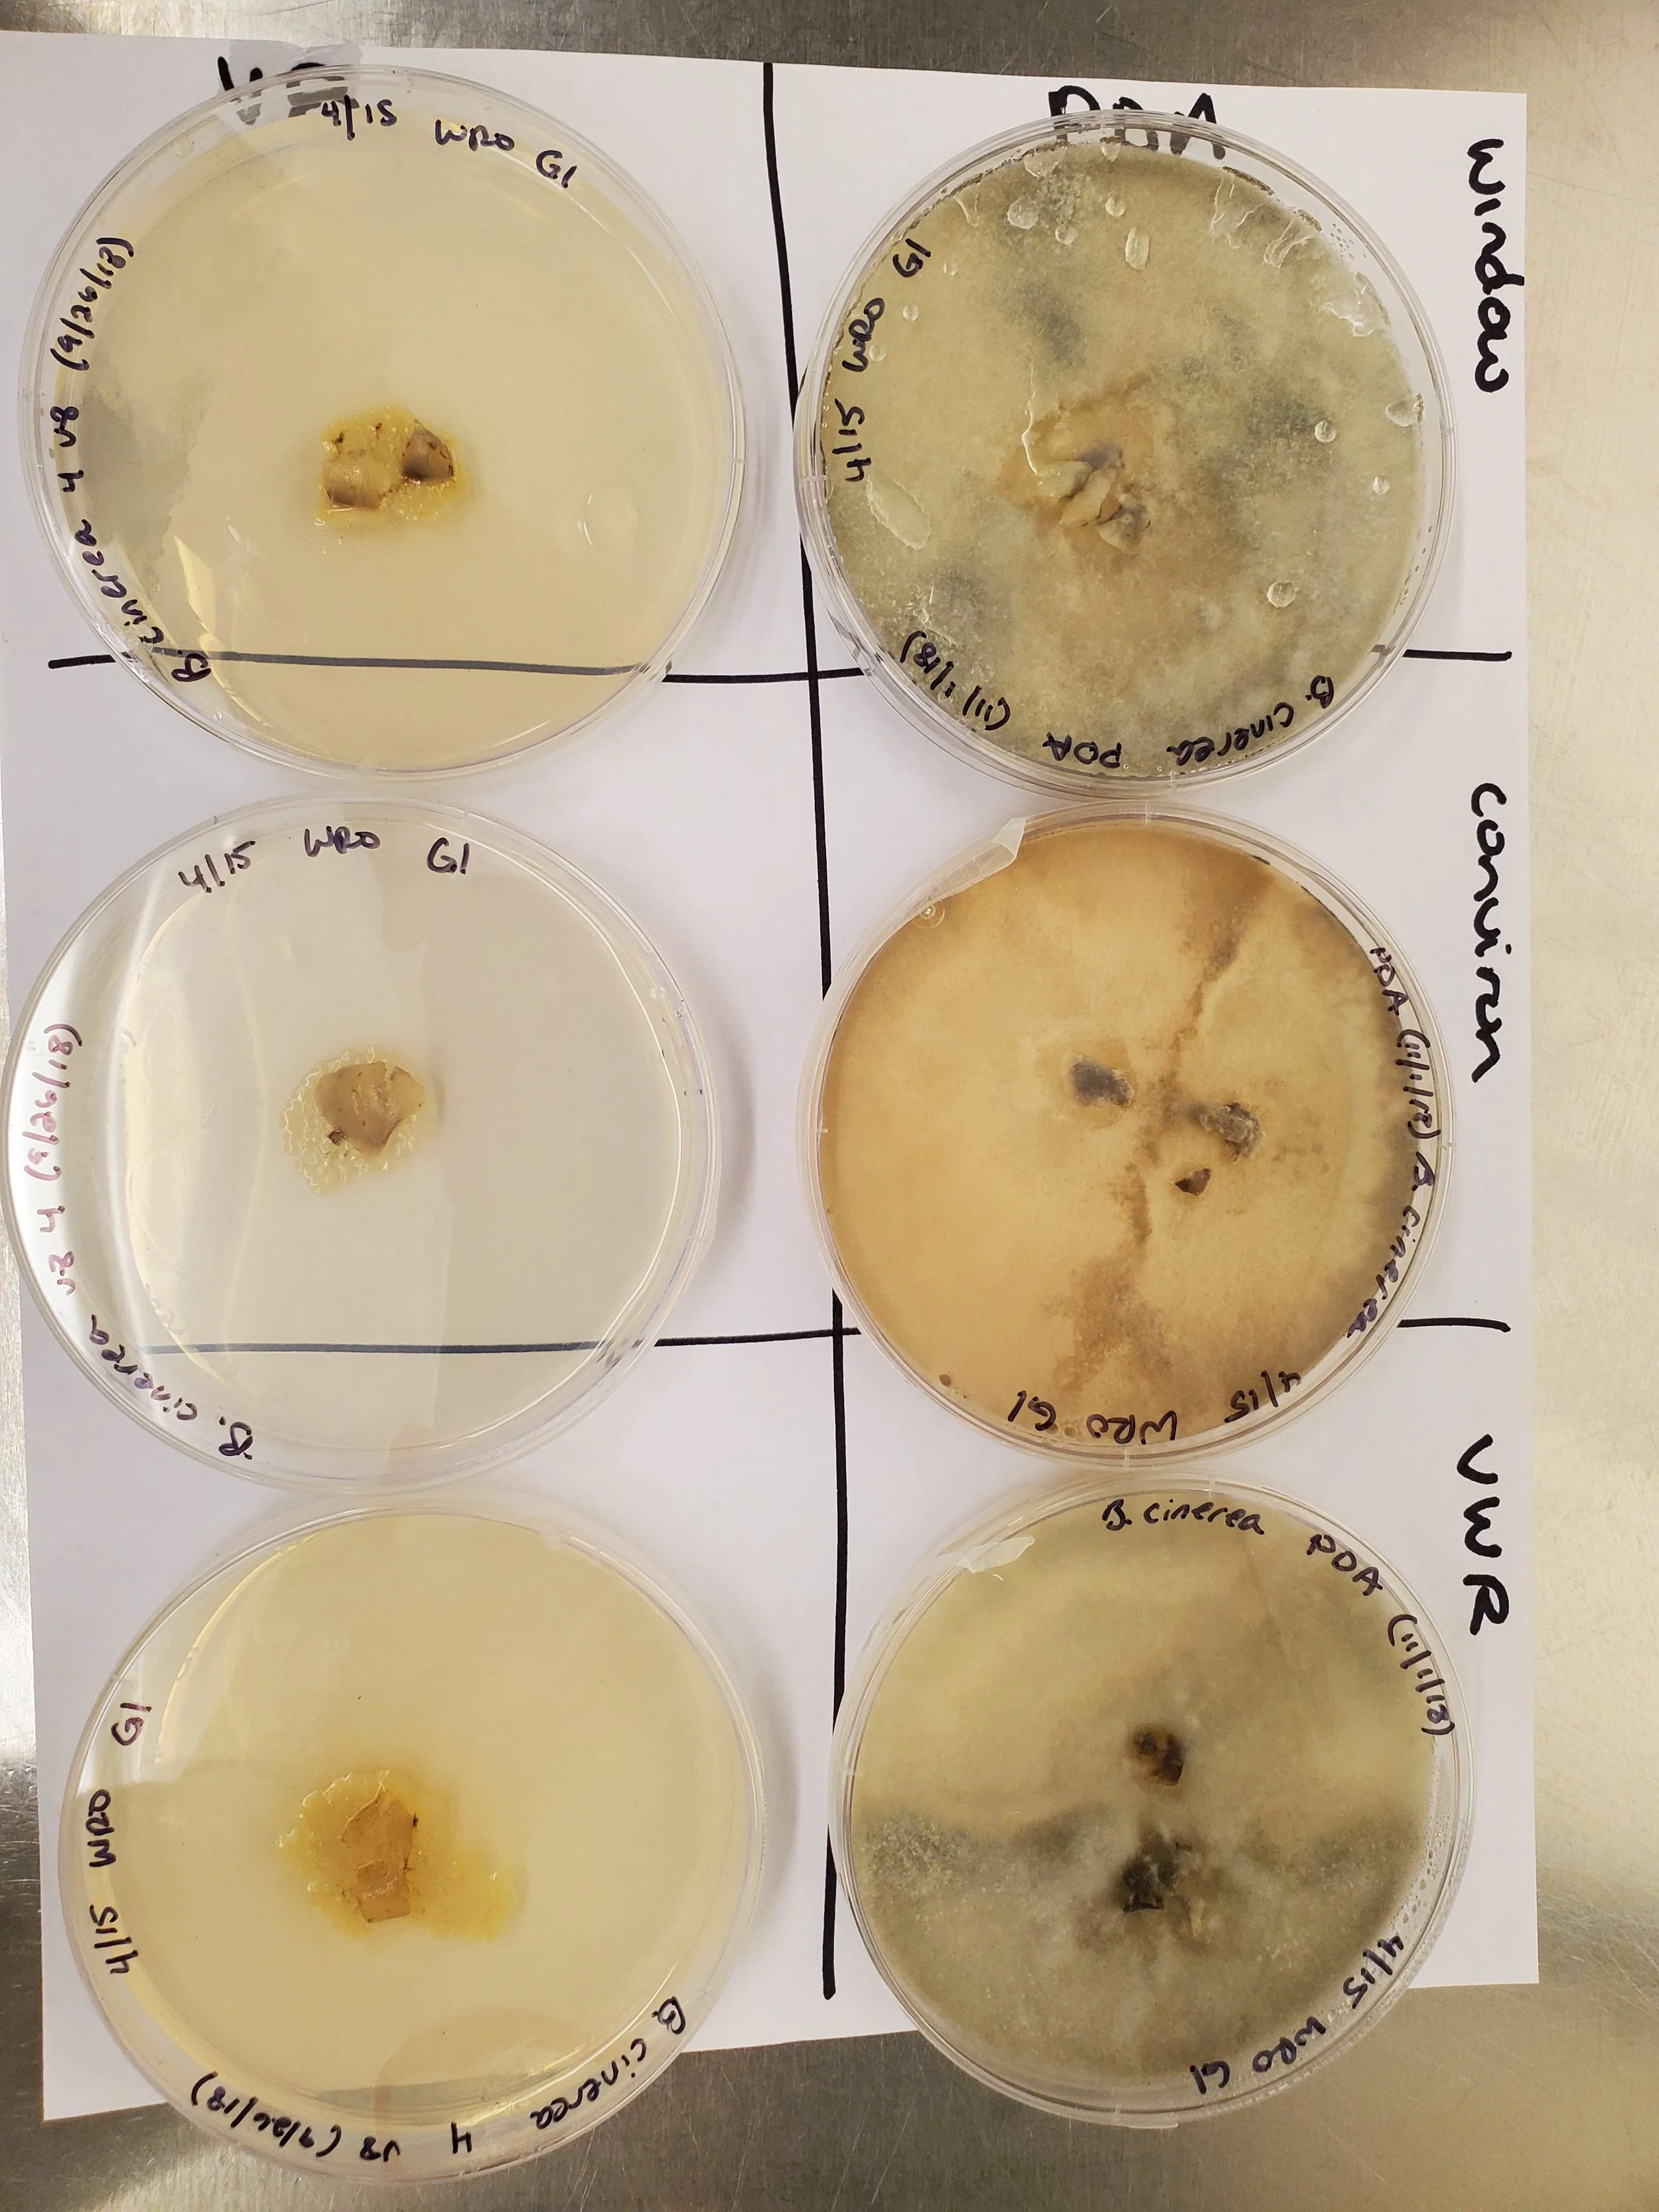
20210423_091921.jpg

My specialty is understanding the complex interactions between a host, a microbiome, and a product’s mode of action within the context of the entire ecosystem. My systems approach to science enables companies to launch thoughtful products that target specific use cases, thus increasing the likelihood of success out in the field or within the animal.
Below is a highlight of my experiences that makes up the foundation of who I am as a business professional.
Animal Science - nutrition, physiology, and lactation.
MBA in Management, Loyola University of Maryland, Baltimore, MD
MS in Animal Science, Pennsylvania State University, University Park, PA
BS in Animal Science, University of Maryland, College Park, MD
My expertise is in intersection of nutritional, rumen, and lactional physiology which means I study what happens inside the rumen after they consume their feed. I leverage my knowledge of physiology to develop products for various animal health and nutrition (AHN) applications that include:
Microbial bedding additives for mastitis control
Bad breath products for companion animals (canines)
Microbial feed additive for methane reduction
Bedding additive for ammonia reduction in poultry houses
Methane and nitrous oxide reduction in manure lagoons
Microbial feed additives for monogastric (porcine) and ruminant gut health
Publications
Rottman, L.W., Ying, Y., Zhou, K., Bartell, P.A., and K.J. Harvatine. The daily rhythm of milk synthesis is dependent on the timing of feed intake in dairy cows. 2014. Physiological Reports.
Rottman, L.W., Ying, Y., Zhou, K., Bartell, P.A., and K.J. Harvatine. The effects of feeding rations that differ in neutral detergent fiber and starch concentration within a day on production, feeding behavior, total-tract digestibility, and plasma metabolites and hormones in dairy cows. 2015. Journal of Dairy Science.
Ying, Y., Rottman, L.W., Crawford, C., Bartell, P.A., and K.J. Harvatine. The effects of feeding rations that differ in neutral detergent fiber and starch concentration within a day on rumen digesta nutrient concentration, pH, and fermentation products in dairy cows. 2015. Journal of Dairy Science.
Salfer, I.J., Crawford, C.E., Rottman, L.W., and K.J. Harvatine. The effects of feeding rations that differ in neutral detergent fiber and starch within a day on the daily patterns of key rumen microbial populations. 2021. JDS Communications.
ABSTRACT. Sarmikasoglou, E., Sumadong, P., Dagaew, G. Johnson M.L., Vinyard, J.R., Salas-Solis, G.K., Siregar, M.U., Rottman, L.W., and A.P. Faciola. Effects of direct fed microbials on in vitro ruminal fermentation, methane production, and ruminal microbial communities. 2023. ASDA Abstract.
Other Collaborations
Dr. Darryl Hadsell (Baylor College of Medicine) - up and down regulation of circadian genes during different nursing frequencies.
Dr. Gregorio Valdez (Virginia Tech’s Fralin Biomedical Research Institute at VTC) - the effects of neuro-muscular diseases on the circadian system.
Dr. DiLorenzo (University of Florida) - the effects of feeding direct-fed microbes (DFM) on enteric methane in beef cattle.
Dr. Faciola (University of Florida) - the effects of feeding direct-fed microbes (DFM) on in vitro enteric methane in dairy cattle.
Dr. Ermias Kebreb (University of Davis) - the effects of feeding direct-fed microbes (DFM) on enteric methane in dairy cattle.
Dr. Hristov (Pennsylvania State University) - the effects of feeding direct-fed microbes (DFM) on enteric methane in dairy cattle and in vitro fermentation.
Microbiology
I have experience in basic and applied microbiology, spore physiology, and precision fermentation. Some of the scientists that mentored me in these areas:
Dr. Jared Heffron, Dr. Joseph Gredell, Dr. Dave Drahos, Dr. Domenic Paone, Dr. Jennifer Nelson, and Dr. Casey Seward
I specialized in understanding the underlying microbial physiology to deduce the mode of action. We then leveraged the mode of action in in agronomic cropping systems mainly row and specialty crops.
Key Accomplishments
Revamped shelf-life stability through robust statistical methods.
Established a new plant pathogen program which enabled the plant pathogen lead to integrate quickly and ramp up the program. I reduced the onboarding process by >6 months.
Developed proprietary microbial screening assays that aided in product development and strain screening.
Developed novel ways to measure microbial modes of action.
Applied Microbiology Gallery
Greenhouse Research
Key Accomplishments
Complete experimental design overhaul that increased reliability and decreased uncertainty. Lead to greater decision making power and decreased every project timeline by >6 months.
Developed an early plant development suite of assays to compliment the long-term plant assays. Increased decision making power and kept project timelines.
Developed quality assurance assays for field trial material to detect major deviations. The result was over $100,000 in field trial cost savings and increased reliability in field trial data.
Created greenhouse mode of action screening assays to further product development.
Assisted team in creating differentiated greenhouse assays that targeted specific project team requests.
Combined principles of regenerative agriculture with greenhouse research.
Crop list
corn
soybeans
canola
bell peppers
cherry tomatoes
cotton
peas
cucumbers
lettuce
Greenhouse Research Gallery